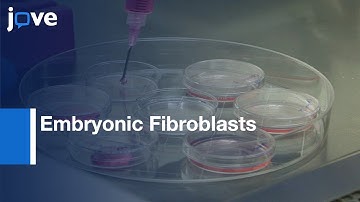
Embryonic Fibroblasts Reprogramming to Induce Hemogenic Program | Protocol Preview

⬇ DOWNLOAD NOW
Jika muncul iklan pop-up, tutup lalu klik tombol kembali
Download lagu Induced Pluripotent Stem Cells: Reprogramming Mouse Embryonic Fibroblasts l Protocol Preview secara gratis hanya untuk keperluan promosi. Dukung artis favorit kamu dengan membeli musik original di iTunes atau platform resmi lainnya.
 Human Induced Pluripotent Stem Cells Reprogrammed From Adult Fibroblasts l Protocol Preview
Human Induced Pluripotent Stem Cells Reprogrammed From Adult Fibroblasts l Protocol Preview Generation: Induced Pluripotent Stem Cells By Reprogramming Human Fibroblasts l Protocol Preview
Generation: Induced Pluripotent Stem Cells By Reprogramming Human Fibroblasts l Protocol Preview Reprogramming Human Somatic Cells into Induced Pluripotent Stem Cells (iPSCs) l Protocol Preview
Reprogramming Human Somatic Cells into Induced Pluripotent Stem Cells (iPSCs) l Protocol Preview Mouse Embryonic Fibroblast Cells: Culturing Human Embryonic l Protocol Preview
Mouse Embryonic Fibroblast Cells: Culturing Human Embryonic l Protocol Preview Induced Pluripotent Stem Cell iPSC
Induced Pluripotent Stem Cell iPSC Embryonic Fibroblasts Reprogramming to Induce Hemogenic Program | Protocol Preview
Embryonic Fibroblasts Reprogramming to Induce Hemogenic Program | Protocol Preview Generation: Mice Derived From Induced Pluripotent Stem Cells l Protocol Preview
Generation: Mice Derived From Induced Pluripotent Stem Cells l Protocol Preview Induced Pluripotent Stem Cells generation using Fibroblast | Protocol Preview
Induced Pluripotent Stem Cells generation using Fibroblast | Protocol Preview